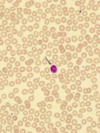
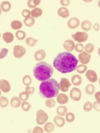
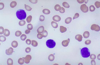

Heme Pathology 3 Flashcards

Myeloblast
Earliest precursor with large, rounder oval nucleus. Fine chromatin, evenly dispersed, few primary granules

Promyelocyte
Nucleus about the same, but the cytoplasm starts to accumulate basophilic granules. Pale regions in nucleus = nucleoli

Neutrophilic Myelocyte
Nucleus round, but chromatin more coarse. More cytoplasm

Metamyelocyte
Kidney bean shaped nucleus
If indentation >1/2 = band

Band
Not segmented into separate lobes yet

Maure Neutrophil
3-5 Lobes
Lymphocyte
Mononuclear cell
Nucleus is the same size as an RBC. Very little cytoplasm

Lymphocyte

Acute Myeloid Leukemia
Malignancy of Myeloblasts. Hypercellular

Acute Myeloid Leukemia
Monoclonal population of -blasts

Acute Myeloid Leukemia
-Blasts

Acute Myeloid Leukemia
R-rod = linear configuration of granules
Only seen in neoplastic myeloblasts

Acute Myeloid Leukemia
R-rods within myeloblasts
Acute Myeloid Leukemia
Acute Promyelocytic leukemia (M3) - cytoplasm filled with granules and some R-rods
>20% blasts to diagnose leukemia
More procoag and fibrinolytic factors in cytoplasm - lead to problems with DIC
Translocation between ch. 15 & 17 T(15,17): PML gene (ch. 15) and Retinoic acid receptor alpha gene (ch. 17) switch –> fusion gene –> fusion protein –> prevents cell from maturing beyond promyelocyte stage. Can target with all-trans retinoic acid to aid maturation.

Acute Myeloid Leukemia
Acute Promyelocytic leukemia (M3) - cytoplasm filled with granules and some R-rods
>20% blasts to diagnose leukemia
More procoag and fibrinolytic factors in cytoplasm - lead to problems with DIC
Translocation between ch. 15 & 17 T(15,17): PML gene (ch. 15) and Retinoic acid receptor alpha gene (ch. 17) switch –> fusion gene –> fusion protein –> prevents cell from maturing beyond promyelocyte stage. Can target with all-trans retinoic acid to aid maturation.

AML

AML (M4/5) Gingival infiltration by leukemia

AML M4/M5
Leukemia Cutis

Normal bone marrow

Chronic Myelogneous Leukemia
Chronic leukemia of myeloid cells. Neoplasm of pluripotent stem cell -> leukocytosis, elevated platelets,

Chronic Myelogneous Leukemia
Full spectrum of hematopoietic precursors

Chronic Myelogneous Leukemia

Chronic Myelogneous Leukemia

Chronic Myelogneous Leukemia